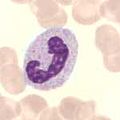
Neutrophiler Granulozyt, stabkernig

Granulozyt
Granulozyten (Singular: der Granulozyt; von lateinisch granulum „Körnchen“ und altgriechisch κύτος kýtos, deutsch ‚Höhlung‘), auch polymorphkernige Leukozyten (von altgriechisch πολύ polý, deutsch ‚viele‘, altgriechisch μορφή morphḗ, deutsch ‚Gestalt‘, altgriechisch λευκός leukós, deutsch ‚weiß‘ und altgriechisch κύτος kýtos, deutsch ‚Höhlung, Gefäß, Hülle‘) und früher auch granulierte Leukocyten genannt, sind bestimmte weiße Blutkörperchen. Sie machen 45 bis 75 % aller weißen Blutkörperchen (Leukozyten) aus.
Es gibt neutrophile, basophile und eosinophile Granulozyten, die je nach Färbeverhalten des Cytoplasmas beschrieben und unterteilt werden und unterschiedliche Funktionen haben. Ihre Aufgabe ist vor allem die unspezifische Bekämpfung (angeborene Immunantwort) von Bakterien, Parasiten und Pilzen. Einige Granulozyten sind dabei in der Lage, Krankheitserreger in sich aufzunehmen und zu zerstören. Diese Granulozyten werden daher zu den „Fresszellen“ gezählt.
Granulozyten werden im Knochenmark gebildet und ins Blut abgegeben. Sie können die Blutbahn auch verlassen und ins Gewebe einwandern. Die Lebensdauer von basophilen Granulozyten beträgt etwa sieben Tage, die von neutrophilen Granulozyten ein bis vier Tage. Der Abbau der Granulozyten erfolgt im mononukleären Phagozytosesystem durch Monozyten.
Die untere Referenzintervallgrenze für Erwachsene liegt bei 2.000/µl.
-
Neutrophiler Granulozyt, stabkernig
Neutrophiler Granulozyt, stabkernig -
 Neutrophiler Granulozyt, segmentkernig
Neutrophiler Granulozyt, segmentkernig -

-

Siehe auch


© biancahoegel.de
Datum der letzten Änderung: Jena, den: 13.07. 2025